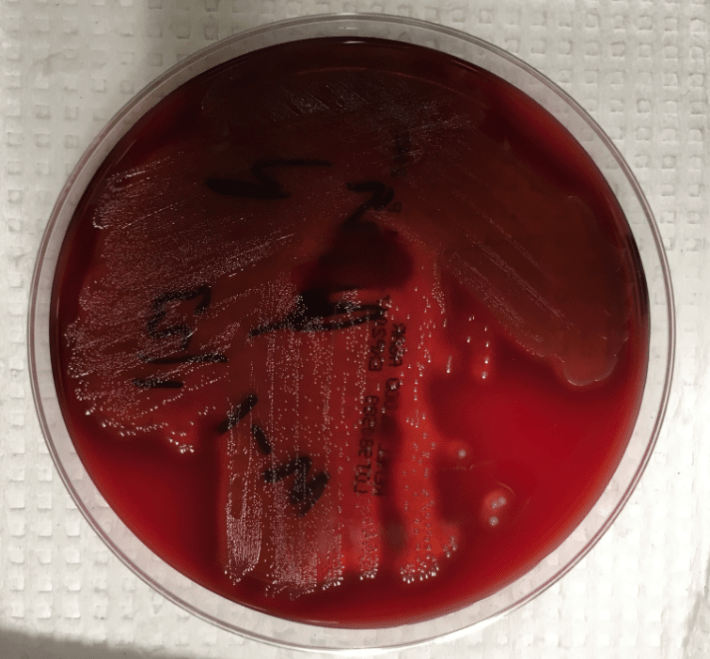
streppyo1

Case History
A 28 year old woman at 37 weeks and 2 days presented in labor to our ED. After 22 hours, she delivered a healthy baby boy and sustained a second degree perineal laceration requiring repair. On hospital day 2, she reported feeling lightheaded, nauseous and “shaky.” She attempted to walk around the unit but became tremulous and unsteady, requiring assistance to get back into bed. Her vital signs were as follows: febrile at 38.8 C, BP 108/54, HR 104 and normal respiration rate at 12 breaths/min. On exam, she appeared pale and lethargic, and was noted to have a tender uterus on palpation. Based on her presentation and status post SVD, the diagnosis of endometritis was established. Blood cultures were obtained and within 16 hours, blood culture bottles were positive for gram-positive cocci. The patient was started on antibiotic therapy with ampicillin, gentamycin and clindamycin, and clinically improved within 36 hours.

Discussion
Streptococcus pyogenes is one of the most aggressive pathogens encountered in clinical microbiology. It is a beta hemolytic streptococcus and is notoriously associated with Streptococcal Toxic Shock Syndrome (STSS), necrotizing fasciitis, as well as more benign (yet still problematic) conditions, like Scarlet Fever, Impetigo, Rheumatic heart disease and Acute Post-streptococcal Glomerulonephritis. A gram-positive cocci, it possesses several virulence factors, including protein F, M protein (involved in antigen mimicry leading to valvular heart disease) hemolysins and exotoxins. These factors allow S. pyogenes to attach to and invade epithelial tissue, and in the case of hyalurondiase, potentially use hyaluron as a carbon food source. S. pyogenes agglutinates with Lancefield group A antisera and is pyrrolidonyl arylamidase (PYR) positive and VP, hippurate and CAMP test negative. Penicillin (PCN) remains the drug of choice in treating most S. pyogenes infections. Alternative antibiotic therapy includes macrolides and certain cephalosporins (e.g. cefixime, cefpodoxime). Vancomycin should be used in more severe infections such as sepsis or for patients with a PCN allergy.
-Christina Litsakos is a Pathology Student Fellow at University of Vermont Medical Center.

-Christi Wojewoda, MD, is the Director of Clinical Microbiology at the University of Vermont Medical Center and an Assistant Professor at the University of Vermont.